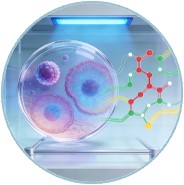

- Home
- Resource
- Explore & Learn
- Unveiling the Dynamics of Poisoning: Introducing Toxicodynetics
- Home
- IVD
- By Technology Types
- By Diseases Types
- By Product Types
- Research
- Resource
- Distributors
- Company
In the realm of clinical toxicology, understanding the temporal evolution of toxic effects following an overdose or poisoning is paramount. Traditional disciplines such as pharmacokinetics (PK) and pharmacodynamics (PD), along with their toxicological counterparts, toxicokinetics (TK) and toxicodynamics (TD), have provided foundational knowledge. However, these fields often fall short in comprehensively describing the time-course of toxic effects. Enter Toxicodynetics, a novel discipline that systematically describes the kinetics of toxic effects over time, bridging the gap between theory and clinical practice.
 Fig.1 Differences between the pharmacokinetics of paclitaxel concentrations in blood and the corresponding toxicodynetic effect on leukocyte count. (Baud F. J., et al., 2016)
Fig.1 Differences between the pharmacokinetics of paclitaxel concentrations in blood and the corresponding toxicodynetic effect on leukocyte count. (Baud F. J., et al., 2016)
Historically, clinical toxicology has focused on identifying toxic substances, understanding their mechanisms of action, and developing antidotes. The time-course of toxic effects, however, was often overlooked or described in a piecemeal fashion. This fragmented approach led to inconsistencies in patient management, particularly in emergency settings where timely interventions are critical.
The concept of toxicodynetics emerged from the need for a more systematic approach to describe the time-dependent progression of toxic effects. It integrates principles from PK, PD, TK, and TD, focusing specifically on the temporal dynamics of poisoning. By doing so, toxicodynetics provides clinicians with a more comprehensive understanding of the poisoning process, enabling more accurate risk assessments and tailored treatment strategies.

Risk Assessment
One of the primary applications of toxicodynetics is in risk assessment. By systematically describing the time-course of toxic effects, clinicians can better predict the severity and duration of poisoning, enabling more informed decisions regarding patient management. For instance, understanding the delay in onset of symptoms can help determine the appropriate period for medical observation, while knowledge of the peak and duration of effects can guide the timing and intensity of supportive treatments.

Drug-Drug Interactions
Toxicodynetics also plays a crucial role in assessing drug-drug interactions. By analyzing the time-course of toxic effects in the presence of multiple toxic substances, clinicians can identify potential synergistic or antagonistic interactions. This information is vital for developing effective treatment strategies and avoiding adverse outcomes.

Treatment Efficacy
Evaluating the efficacy of antidotes and supportive treatments is another key application of toxicodynetics. By comparing the time-course of toxic effects before and after treatment, clinicians can assess the effectiveness of interventions. For instance, toxicodynetic analysis can reveal whether an antidote shortens the duration of toxic effects or reduces their severity.

Experimental studies in animal models are instrumental in advancing toxicodynetics. These studies allow for controlled exposure to toxic substances, enabling detailed analysis of the time-course of toxic effects. For example, studies in rats have provided valuable insights into the respiratory effects of organophosphorus and carbamate insecticides, revealing dose-dependent patterns of toxicity.
In vitro models, such as cell cultures and tissue explants, also contribute to toxicodynetic research. These models allow for the study of cellular and molecular mechanisms underlying toxic effects, providing complementary information to in vivo studies. For instance, in vitro studies can reveal the time-dependent activation of signaling pathways in response to toxic substances.

Advanced data analysis and mathematical modeling techniques are essential for toxicodynetic research. These techniques enable the quantification of toxic effects over time, facilitating comparisons between different substances and treatment strategies. For example, modeling the AUCE can provide insights into the overall exposure to toxic effects, while more complex models can account for delays and non-linear relationships between dose and effect.
If you have related needs, please feel free to contact us for more information or product support.
Reference
This article is for research use only. Do not use in any diagnostic or therapeutic application.
|
There is no product in your cart. |